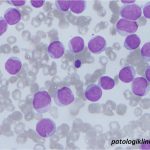
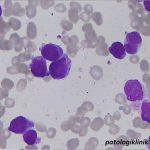
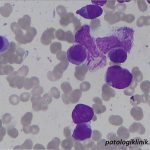
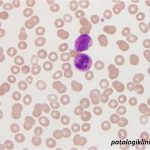

Auer Rod

Auer rod (batang auer rod) merupakan gambaran berbentuk seperti jarum atau garis berwarna merah yang dapat ditemukan pada sitoplasma mieloblas dan promielosit pada beberapa tipe leukemia. Auer rod terbentuk dari fusi abnormal granul azurofilik. Auer rod bisa ditemukan berupa satu garis atau multipel yang bertumpuk.
Identifikasi auer rod sangat penting karena jika ditemukan menunjukkan adanya keganasan mieloid, bisa pada berbagai tipe leukemia mieloblastik akut dan CML fase krisis blast.

![[Download] Pedoman Nasional Pelayanan Kedokteran Tata Laksana Thalassemia (KMK)](/content/images/uploads/2022/10/KMK.jpg)
![[Download] Pemeriksaan Laboratorium pada Thalassemia](/content/images/uploads/2022/09/cover-web-scaled.jpg)